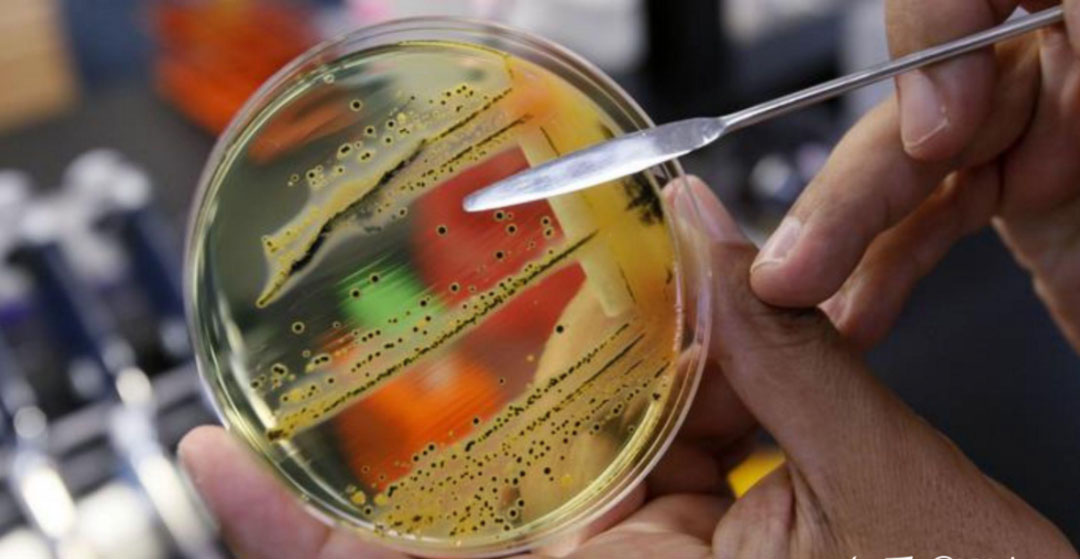

-
2025-9-16
類器官缺陷之成熟度不足
-
2025-9-9
促成當代類器官出現(xiàn)的條件
-
2025-9-2
類器官是什麽
-
2025-8-26
科研界的“美(měi)猴王” -到底如何稱呼它?
-
2025-8-19
誰是我的(de)“鄰居”—實驗動物多物種混養指導原則
-
2025-8-12
《結核分枝杆(gǎn)菌感染檢測技術應用專(zhuān)家共識》對實驗猴(hóu)結核檢測的啟(qǐ)示
-
2025-8-5
雪貂的麻醉與止痛-上
-
2025-7-29
淺談實驗動物獸醫的“獨(dú)立性”
-
2025-7-22
五領域模型的演化與升級(jí)
-
2025-7-15
從“五自由”到“五領域(yù)” — 動物福利理念的升級之(zhī)路
實驗動物設施的抗菌藥物管理
引(yǐn) 言
細菌對抗菌藥物的耐(nài)藥性(xìng)已演變成全(quán)球性健康危機。醫生(shēng)與獸(shòu)醫逐漸接納 “抗菌藥(yào)物管理”(AMS)理念,力求長期維持抗生素療效。AMS主張全麵、係統地遴選與使用抗生素,以保障其藥效的可持續性。2007年,美國感染病學會和美國醫療保健流行病學學會針對(duì)人類醫院的AMS項目(mù)發布正式指南。但在(zài)獸醫學領域,AMS尚屬較(jiào)新觀念。食用動物養殖中,抗菌藥物作為生長促進劑使用,因可能引發耐藥菌滋生與傳播,已被嚴格管控。近期(qī),不少文獻呼籲伴侶動物從業者積(jī)極推行AMS實踐,如在(zài)獸醫(yī)醫院設立正式AMS項目。研究顯示,無論有無正式AMS項目,關於細菌耐藥性和AMS的知識(shí)普及,都能降低抗生(shēng)素處方頻率(lǜ)與療程,減少不合理用(yòng)藥。
在實驗動(dòng)物領域,抗菌藥物用於臨床疾(jí)病治療、保護易感動物群體,以及微生物組研究(jiū)、調控基因工程動物表達等科研項目。推動抗生素合理使用,旨在保障臨床護理(lǐ)與科(kē)研支持質量的同時,降低細菌(jun1)耐藥(yào)性風險。實驗動物領域常用 “3R” 原則,即替代(Replace)、減少(Reduce)和優化(Refine),來倡導合理使用實驗動物,近期這一原則在獸醫學文獻中也用於支撐 AMS 理(lǐ)念。還有觀點主張采用 “5R” 方法開展(zhǎn) AMS,即在 “3R” 基(jī)礎上新增審查(Review)和責(zé)任(Responsibility)。
Part.01減少實驗動物對抗生(shēng)素的使用
抗生素開具需遵循嚴格必要原則。人類醫學(xué)中,抗生素常被錯用於治療病毒引發的呼吸(xī)道疾病,兒童群體尤為突出(chū)。實驗動物領域,病毒導致的臨床疾病相對少見,抗生素部分用於確診細菌感染,部分屬經驗性(xìng)用藥。AMS 策略規(guī)定,給實驗動物用抗生素前必須先診斷。一般而言,開抗生素處方前,要排查(chá)並確定細菌種(zhǒng)類、存在情(qíng)況及對抗生(shēng)素的敏感性。齧齒動物(wù)和非人靈長類動物易出現皮(pí)膚(fū)損傷,因病原菌分離株與(yǔ)共生菌群難區分,常導致經驗(yàn)性治療。小型動物獸醫通常建議通過細胞學檢查診(zhěn)斷皮膚感染,深(shēn)部或難治性感染則需細菌(jun1)培(péi)養和藥敏試驗。
與其他獸醫不同,實驗動物獸醫較少受客戶(科研人員)不合理的抗生(shēng)素使用壓力。隨著人類醫學和伴侶動物獸醫(yī)學對經驗性用抗菌素審查趨(qū)嚴(yán),科研人員可能質疑實驗動物臨床用抗生素,甚至將其視為研究中不可接受的變量。
Part.02優化實驗動物中抗生素的使用
抗生素使用方式在其(qí)應用過(guò)程中起著關鍵(jiàn)作用。傳統依據最低抑菌濃度(Minimum Inhibitory Concentration, MIC)確定劑量,MIC 指理論(lùn)上抑製細菌生長的最低(dī)抗生素濃度。但 MIC 反映的是特定條件(jiàn)下的穩態藥物濃度,未考慮達(dá)到穩態前(qián)可能的(de)耐藥菌篩選問題。當(dāng)下耐藥菌廣泛傳播,MIC 可能低估(gū)控製感染所需劑量,尤其在肺部、中樞神經係統等部位。而且多數抗生素的 MIC 基於人類研究,小型實驗動物如齧齒動(dòng)物代謝率高,很多藥物難達 MIC 標準。小鼠和大鼠用抗生素後較少出現明顯毒性反應,因其(qí)對與抗生素相關(guān)的梭菌過度生長抵(dǐ)抗力強。不過(guò),使(shǐ)用(yòng)抗生素時仍要密切監測動物有(yǒu)無毒性跡象(xiàng)和不良反應。
抗生素(sù)特性決定(dìng)給藥方式。磺胺類(lèi)等時間依賴性抗生素(sù),療效取決於(yú)藥物血漿濃度超 MIC 的持續(xù)時間;氟喹諾酮類等濃度依賴性抗生素,靠血漿峰濃度發揮作用。時間依賴性抗生素通過飼料、飲水腸內(nèi)給藥效果可能較好;濃度依賴性(xìng)抗生素則更適合腸胃外(wài)注射(大劑量)給藥。對研究用齧齒動物(wù),食物(wù)或飲(yǐn)水給藥優勢明顯(xiǎn),因局部或腸(cháng)胃外治療需保定動物,會帶來應激,幹擾研究結果。
獸醫學實踐中,抗生素在外科手術、重症監護、內科、皮膚科廣泛應用(yòng)。小鼠和非人靈長類動物疾病裏,皮膚問(wèn)題(皮炎、打鬥傷口)占比大。小(xiǎo)型動物獸醫實踐指南建(jiàn)議,研究用齧齒動物多數皮膚損傷(局灶性(xìng)表麵損傷)優先用局部抗生素,而非全身用藥。一些小鼠群體中,眼部損傷發病率僅次於皮膚損傷,全身用藥難作用於眼部,眼部感染應采用局部抗菌藥物治療。局部感染(如膿腫)切開引流即可,通常無需用抗生素。大型實驗動物如非人靈長類動物和狗常用注射用抗生素治療,近年長效單劑(jì)量注射用(yòng)抗生素製劑應用受提(tí)倡。大(dà)麵積創(chuàng)傷性損傷和全身性(xìng)感染,特(tè)別是免(miǎn)疫功能低下動物的此(cǐ)類感染,可能需用全身性抗(kàng)生素,但應在臨床允許的最短時間(jiān)內給藥。
Part.03替代實驗動物中的抗生(shēng)素使用
即便診斷支持用抗生素(包括局部抗生素),也需謹慎。人類傷口護理中,局部抗生素已出(chū)現細菌耐藥現象(xiàng),皮膚科醫生更多推薦非(fēi)抗生素類局部治療方法(fǎ)處(chù)理淺表傷口和皮膚感染。小型動物(wù)獸醫皮膚(fū)科常用局部防腐(fǔ)劑(含或(huò)不含抗生素)治療,也有建議用洗必泰溶液治療齧齒動物皮膚損傷(shāng)。同時,非藥物(wù)幹預措施也值得關注。修剪指甲可減少抓撓導致的皮膚(fū)和軟組(zǔ)織損傷。環境(jìng)調整,如在籠子裏增加物品(pǐn)分散動物抓撓注意力,可能有效果。更換籠子時,轉移少量原髒籠子(zǐ)墊(diàn)料到新(xīn)籠子,利用(yòng)氣味標記維持等級秩序,減少動物攻擊性;優化籠子(zǐ)內部(bù)設施,也可能降低(dī)小鼠打鬥行為。
避免細菌感染是替代抗生素使用的最佳方案。為研究人員提供無菌手術技術培訓,給予協助、空間、設備和物資支(zhī)持,可使多數手術(shù)無需預防性用抗(kàng)生(shēng)素。非一次性器械用後要(yào)清潔消毒,剃毛刀刀片需高壓滅菌。手術前,耗材和植入(rù)物應嚴格滅菌。改進籠子設計有助於齧齒動物感染控製,飼養籠內氣壓高於房間(jiān)氣壓雖(suī)可能增加員工接觸過敏原風險,但對免疫缺(quē)陷品係等(děng)易感(gǎn)染齧齒(chǐ)動物,能更好抵禦細菌感染,減少預防性用抗生素需求。更換籠子及其他動物操作(zuò)時采用微隔離技術,優先處理易感染動物(如工作日早些時候),也可能降低感染(rǎn)發生率。
Part.04審查實驗(yàn)動物中的抗生素使用
需定期審查個體實驗(yàn)動物和整體動物群(qún)體的抗生素使用情況。若診斷前就用了抗生素,應依據檢測結果(guǒ)優化(huà)或(huò)調(diào)整治療方案。診斷實(shí)驗室應(yīng)按臨床與實驗室標準協會發(fā)布的指南,在機構(gòu)或區域層麵生成年度累(lèi)積抗菌譜。人類醫院通過(guò)量化臨(lín)床抗生素使用情況(如(rú)抗菌藥物治療(liáo)天數(shù))識別用藥模式,評(píng)估 AMS 措施和項目有效性。研究機構中,獸醫、獸醫技術人員和診斷(duàn)實驗室人員就抗菌藥物使用展開討論評估,是建立 AMS 措施的重要開端。最終,實驗動物領域應借鑒其他獸醫專業組織經驗,製定實驗動(dòng)物抗菌藥物合理(lǐ)使用指南。
Part.05為實驗動(dòng)物合理(lǐ)使用抗生素擔責
動物實驗項目和飼(sì)養室管理(lǐ)影響抗菌藥物使用、耐藥菌產生傳(chuán)播及人畜共患病,這些又反過來影響飼養室工作人員、研究人員及公(gōng)眾健康安全。動物飼養室用過的抗生素(sù)(如齧齒動物飲用水中的)應作(zuò)為化學廢物妥善(shàn)處理,不能倒入下水道,防止汙染地(dì)下水,增加環境耐藥菌數量,市政汙水排放許可對抗生素排放(fàng)有限製。部分 AMS 改(gǎi)進措施易實施,部分則需觀念轉變,需要個(gè)體切實承擔(dān)抗菌藥物管理責任。
結論
負責照料實驗動物的(de)人員在抗生素使用方麵麵臨著相互矛盾(dùn)的責任。遵循獸醫(yī)護理標準、關懷患病動物可能致抗生素過度使(shǐ)用;但又需平衡維護公眾健(jiàn)康責任,減少(shǎo)耐藥菌產生,維持抗生素療效。如(rú)同其他臨(lín)床學(xué)科,實驗動物(wù)醫學抗生素使用應依 AMS 理念優化。“5R 原則” 為 AMS 實施提供指導:減少抗生素使用,僅(jǐn)對確診細菌感染且經(jīng)許可研究項目中的動物用藥;根據動物種類、感染特征和藥物特性,優化劑量、給藥途徑(jìng),縮短治療時(shí)長;盡量用非抗生素藥物和其他幹預措施替代抗(kàng)菌藥物,改善衛生清潔預防感染,避免不必要用藥;定期審查個體和群體抗生素需求;最重要的是,切實為(wéi)實(shí)驗動(dòng)物抗菌藥物合理使用擔責。如此,才能保障實驗動物健康、科研順利,同時應對細菌耐藥性挑戰,維護公眾健康。